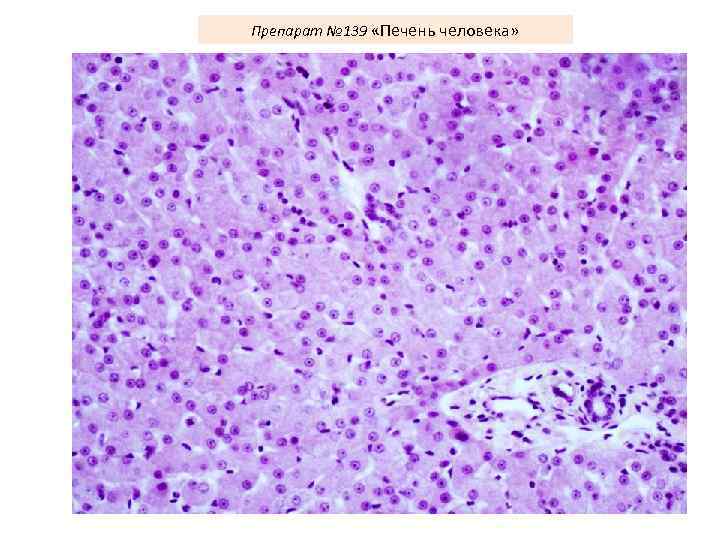
Препарат № 139 «Печень человека»

Пищеварительные железы.ppt
- Количество слайдов: 82

ПИЩЕВАРИТЕЛЬНЫЕ ЖЕЛЕЗЫ Кафедра гистологии, эмбриологии и цитологии лечебного факультета

Околоушная слюнная железа Язык Глотка Пищевод Печень Желчный пузырь Желудок Селезенка Поджелудочная железа Толстая кишка Тонкая кишка Прямая кишка (12 -ти перстная, тощая, подвздошная)

Источники развития крупных пищеварительных желез ЭКТОДЕРМА Слюнные железы ЖЕЛЕЗИСТАЯ ПАРЕНХИМА (концевые отделы и выводные протоки) СОСУДЫ, СТРОМА ЭНТОДЕРМА Печень, поджелудочная железа МЕЗЕНХИМА ЖЕЛЕЗИСТАЯ ПАРЕНХИМА (концевые отделы и выводные протоки) СОСУДЫ, СТРОМА

Околоушная слюнная железа Язык Подъязычная слюнная железа Поднижнечелюстная слюнная железа

СТРОЕНИЕ СЛЮННЫХ ЖЕЛЕЗ Миоэпителиальные клетки присутствуют во всех концевых отделах, вставочных и исчерченных протоках


Слюнные железы : - Отличаются концевыми отделами - Общий принцип организации выводных протоков: • Вставочный проток – кубический эпителий • Исчерченный проток (слюнная трубка) призматический эпителий • Внутридольковый проток – двухслойный эпителий • Междольковый проток – многослойный эпителий Во всех концевых отделах, вставочных и исчерченных протоках присутствуют миоэпителиальные клетки


Поднижнечелюстная железа (вставочный проток)

Подъязычная железа (исчерченный проток)

Внутридольковый и исчерченные протоки поднижнечелюстной железы

Околоушная железа (междольковый проток)

Препарат № 135 «Околоушная железа»

Междольковые протоки околоушной железы

Исчерченный и вставочный протоки околоушной железы

Вставочный и внутридольковый протоки околоушной железы

Исчерченный и вставочный протоки околоушной железы

Исчерченный проток околоушной железы

Междольковый проток околоушной железы

Препарат № 136 «Поднижнечелюстная железа»

Внутридольковый и исчерченный протоки поднижнечелюстной железы

Вставочный проток поднижнечелюстной железы

Концевые отделы поднижнечелюстной железы

Триада - междольковый проток, артерия и вена

Исчерченный проток поднижнечелюстной железы

ПЕЧЕНЬ Спиральный клапан Проток желчного пузыря Желчной пузырь Сфинктр общего желчного протока Печеночный проток Общий желчный проток Главный проток поджелудочной железы Сфинктр главного протока поджелудочной железы Фатеров сосочек Ампула Сфинктр гепатопанкреатической ампулы




ПЕЧЕНЬ ЧЕЛОВЕКА



капилляр



капилляр

Холангиола

CV- центральная вена BD- желчные протоки * - синусоидные капилляры

Поры в эндотелии синусоидных капилляров

1 - внутридольковый синусоидный капилляр, 2 - эндотеиальная клетка, 3 - поры в эндотелии, 4 - звездчатый макрофаг, 5 - перисинусоидальное пространство Диссе, 6 - ретикулярные волокна, 7 - микроворсинки гепатоцитов, 8 - гепатоциты, 9 - желчный капилляр, 10 - перисинусоидальный липоциты (клетки Ито), 11 - жировые включения, 12 - эритроциты

Желчный капилляр Плотный контакт Десмосома Звездчатый макрофаг (Купферовская клетка) Эндотелиоцит Перисинусоидальное пространство Диссе Ретикулярное волокно Липоцит Ямочная клетка Плотный контакт Ретикулярное волокно


Ретикулярные волокна

Гликоген в гепатоцитах. Синусоиды, центральная вена

Купферовские клетки

Купферовские клетки


Междольковый желчный проток 1 - просвет желчного протока, 2 - ядра эпителиоцитов, 3 - микроворсинки, 4 - десмосома, 5 - плотные контакты, 6 - базальная мембрана

Синусоидный капилляр печени 1 -эндотелий с порами, 2 - пространство Диссе

Желчный капилляр печени 1 - ядро, 2 -митохондрия, 3 - лизосома с желчными пигментами, 4 - желчный капилляр

Желчный капилляр

Обменные и секреторные процессы в гепатоцитах


1 - зона оптимального кровоснабжения, 2 - зона умеренного кровоснабжения, 3 - зона наихудшего кровоснабжения (наиболее уязвима при интоксикациях)

Препарат № 138 «Печень свиньи»

Триада печени

Препарат № 139 «Печень человека»
Препарат № 139 «Печень человека»

Препарат № 139 «Печень человека»

Триада печени

Печень человека. Окраска кармином (выявление сосудов)

Центральная вена и синусоидные капилляры

Строение стенки желчного пузыря

Препарат № 140 «Желчный пузырь (и фрагмент печени)»




ПОДЖЕЛУДОЧНАЯ ЖЕЛЕЗА




Межацинарный проток

Ацинус и вставочный проток поджелудочной железы

Ациноциты и центроацинозная клетка

Ациноцит поджелудочной железы

Панкреатический островок А клетки – глюкагон В-клетки – инсулин D-клетки – соматостатин D 1 -клетки – вазоактивный интестинальный пептид РР-клетки - панкреатический полипептид


Препарат № 139 «Поджелудочная железа»

Вставочный и межацинарный протоки поджелудочной железы

Междольковый проток поджелудочной железы (однослойный эпителий)

Пластинчатые тельца

Зимогенные гранулы
Пищеварительные железы.ppt